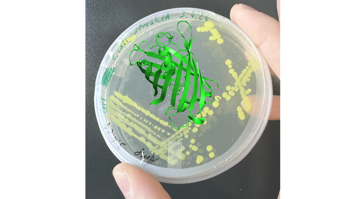
GFP Protein

Mitmachstation
Warum ist Chemie die Magie des Alltags?
Thema:
Naturwissenschaften
Schlagworte:
Chemie
Altersgruppe:
Alle
Maximale Kapazität der Station: 30 Personen
Besucherinformation
Anfahrtsbeschreibung: Ein kostenloser Shuttlebus fährt alle 30 Minuten zu diesem Standort (Haltestelle bei Kepler Hall). Fahrplan siehe Infobox! Sie können die Johannes Kepler Universität Linz am besten mit den Öffis (Straßenbahnlinie 1 und 2) aber auch mit PKW erreichen. Wir empfehlen die Anreise mit öffentlichen Verkehrsmitteln.
Dieser Ausstellungsstandort ist barrierefrei zugänglich und verfügt über barrierefreie Toiletten.
Johannes Kepler Universität Linz
JKU Open Lab
Öffnungszeiten
Erster Einlass: 17:00
Letzter Einlass: 23:00
67 weitere Stationen an diesem Standort
-
 MitmachstationWolpertinger in Linz gesichtet oder: Welchen Schlagzeilen können Sie vertrauen?Thema: Digitalisierung GesellschaftBetreten Sie eine lebhafte News-Redaktion und entscheiden Sie: Ist diese Schlagzeile wahr oder irreführend? Erleben Sie, wie Emotionen, Vorurteile und sozialer Einfluss unser Urteilsvermögen prägen. Testen Sie Ihre Intuition und schärfen Sie Ihr kritisches Denken in einer Welt, in der sich Fehlinformationen rasend schnell verbreiten.Johannes Kepler Universität Linz17:00 - 23:00
MitmachstationWolpertinger in Linz gesichtet oder: Welchen Schlagzeilen können Sie vertrauen?Thema: Digitalisierung GesellschaftBetreten Sie eine lebhafte News-Redaktion und entscheiden Sie: Ist diese Schlagzeile wahr oder irreführend? Erleben Sie, wie Emotionen, Vorurteile und sozialer Einfluss unser Urteilsvermögen prägen. Testen Sie Ihre Intuition und schärfen Sie Ihr kritisches Denken in einer Welt, in der sich Fehlinformationen rasend schnell verbreiten.Johannes Kepler Universität Linz17:00 - 23:00 -
 AusstellungForscherinnen* im Fokus: Wie werden Frauen* an der JKU gefördert?Thema: Gesellschaft KulturZu ihrem 60. Jahr der Gründung zeigt die JKU die Ausstellung "Viel erreicht, noch mehr zu tun" über die Entwicklung der Frauenförderung an der Universität. Geschichtliches und aktuelle Maßnahmen werden kurzweilig präsentiert und von eigens für die Ausstellung angefertigten Illustrationen von Carolin Aichhorn begleitet. Zudem werden die fünf Gewinnerinnen* des „Forscherinnen* im Fokus“-Preises vorgestellt.Johannes Kepler Universität Linz17:00 - 23:00
AusstellungForscherinnen* im Fokus: Wie werden Frauen* an der JKU gefördert?Thema: Gesellschaft KulturZu ihrem 60. Jahr der Gründung zeigt die JKU die Ausstellung "Viel erreicht, noch mehr zu tun" über die Entwicklung der Frauenförderung an der Universität. Geschichtliches und aktuelle Maßnahmen werden kurzweilig präsentiert und von eigens für die Ausstellung angefertigten Illustrationen von Carolin Aichhorn begleitet. Zudem werden die fünf Gewinnerinnen* des „Forscherinnen* im Fokus“-Preises vorgestellt.Johannes Kepler Universität Linz17:00 - 23:00 -
 AusstellungWie wächst Nachhaltigkeit auf unserem Campus?Thema: Technik UmweltDas Projekt "Roots of Change" macht Nachhaltigkeit an der JKU sichtbar und erlebbar. Besucher:innen entdecken eine interaktive Installation, erfahren, wie aus Kunststoff-Recyclingmaterial neue Blumentöpfe entstehen, und können beim Quiz selbst aktiv werden. Wer teilnimmt, hat die Chance, einen nachhaltig produzierten JKU Topf zu gewinnen.Johannes Kepler Universität Linz17:00 - 23:00
AusstellungWie wächst Nachhaltigkeit auf unserem Campus?Thema: Technik UmweltDas Projekt "Roots of Change" macht Nachhaltigkeit an der JKU sichtbar und erlebbar. Besucher:innen entdecken eine interaktive Installation, erfahren, wie aus Kunststoff-Recyclingmaterial neue Blumentöpfe entstehen, und können beim Quiz selbst aktiv werden. Wer teilnimmt, hat die Chance, einen nachhaltig produzierten JKU Topf zu gewinnen.Johannes Kepler Universität Linz17:00 - 23:00 -
 FührungBlumen und Bienen statt Beton: Wie nachhaltig ist der JKU Campus?Thema: EnergieGemeinsam entdecken wir an dieser Station die Vielfalt der Lebewesen am Campus, entdecken Lebensräume und entwickeln einen Blick für die Schönheit der Natur rund um die Universität. Aber auch moderne nachhaltige Technik, die uns den Weg zur Klimaneutralität öffnen wird, kommt nicht zu kurz. Machen Sie sich auf eine Reise, die in die Zukunft führt!Johannes Kepler Universität Linz17:00 - 23:00
FührungBlumen und Bienen statt Beton: Wie nachhaltig ist der JKU Campus?Thema: EnergieGemeinsam entdecken wir an dieser Station die Vielfalt der Lebewesen am Campus, entdecken Lebensräume und entwickeln einen Blick für die Schönheit der Natur rund um die Universität. Aber auch moderne nachhaltige Technik, die uns den Weg zur Klimaneutralität öffnen wird, kommt nicht zu kurz. Machen Sie sich auf eine Reise, die in die Zukunft führt!Johannes Kepler Universität Linz17:00 - 23:00 -
 FührungAuf Keplers Spuren: Welche Geheimnisse bietet der JKU Campus?Thema: Gesellschaft NaturwissenschaftenEntdecken Sie den JKU Campus! Prof. Julian Reiss führt Sie zu jenen Orten, die unsere Universität mit ihrem Namensgeber verbinden. Evelin Stockinger nimmt Kinder ab 6 Jahren mit auf einen Rundgang und bringt ihnen den Campus im Form eines Märchens näher. Dabei sein lohnt sich! Der Märchenrundgang findet um 18.00 Uhr statt, die Campustour von Prof. Reiss um 19.00 Uhr.Johannes Kepler Universität Linz18:00 - 19:00 (Anmeldung erforderlich)
FührungAuf Keplers Spuren: Welche Geheimnisse bietet der JKU Campus?Thema: Gesellschaft NaturwissenschaftenEntdecken Sie den JKU Campus! Prof. Julian Reiss führt Sie zu jenen Orten, die unsere Universität mit ihrem Namensgeber verbinden. Evelin Stockinger nimmt Kinder ab 6 Jahren mit auf einen Rundgang und bringt ihnen den Campus im Form eines Märchens näher. Dabei sein lohnt sich! Der Märchenrundgang findet um 18.00 Uhr statt, die Campustour von Prof. Reiss um 19.00 Uhr.Johannes Kepler Universität Linz18:00 - 19:00 (Anmeldung erforderlich) -
 AusstellungKann KI Recht?Thema: DigitalisierungKünstliche Intelligenz transformiert das Steuerrecht und führt zu wesentlichen Änderungen in der Arbeitsweise sowie im Leistungsangebot der Steuerberatung. Wir zeigen Anwendungen Künstlicher Intelligenz für verschiedene steuerrechtliche Fälle – eine faszinierende Mischung aus moderner Technologie und steuerrechtlicher Expertise.Johannes Kepler Universität Linz17:00 - 23:00
AusstellungKann KI Recht?Thema: DigitalisierungKünstliche Intelligenz transformiert das Steuerrecht und führt zu wesentlichen Änderungen in der Arbeitsweise sowie im Leistungsangebot der Steuerberatung. Wir zeigen Anwendungen Künstlicher Intelligenz für verschiedene steuerrechtliche Fälle – eine faszinierende Mischung aus moderner Technologie und steuerrechtlicher Expertise.Johannes Kepler Universität Linz17:00 - 23:00 -
 MitmachstationOpen Strategy Playground – wie kann man wichtige Entscheidungen gemeinsam treffen?Thema: WirtschaftWie sieht offenes Organisieren als Tanz aus? Wie einigen wir uns auf unser Urlaubsziel? Wie kann ich meine Ziele visualisieren? Wie viel Taschengeld soll ich bekommen? An dieser Station probieren wir aus, wie uns strategisches Denken im Alltag hilft Zukunft zu gestalten, mit unterschiedlichen Perspektiven umzugehen und gemeinsame Ziele zu definieren. Es erwartet Sie eine Tanzperformance um 19.00, 20.00 & 21.00 Uhr.Johannes Kepler Universität Linz17:00 - 23:00
MitmachstationOpen Strategy Playground – wie kann man wichtige Entscheidungen gemeinsam treffen?Thema: WirtschaftWie sieht offenes Organisieren als Tanz aus? Wie einigen wir uns auf unser Urlaubsziel? Wie kann ich meine Ziele visualisieren? Wie viel Taschengeld soll ich bekommen? An dieser Station probieren wir aus, wie uns strategisches Denken im Alltag hilft Zukunft zu gestalten, mit unterschiedlichen Perspektiven umzugehen und gemeinsame Ziele zu definieren. Es erwartet Sie eine Tanzperformance um 19.00, 20.00 & 21.00 Uhr.Johannes Kepler Universität Linz17:00 - 23:00 -
 MitmachstationSensoren im Alltag: Wie wird das Internet of Things unser Leben ändern?Thema: DigitalisierungBegreifen Sie das Internet of Things (IoT): Bauen Sie eine IoT-Applikation und erfahren Sie, was das Internet der Dinge leisten kann. Die Station hilft Ihnen, den Prozess der Systemgestaltung bis hin zum Sensemaking aus der Perspektive der digitalen und gleichzeitig menschenzentrierten Entwicklung besser zu verstehen.Johannes Kepler Universität Linz17:00 - 23:00
MitmachstationSensoren im Alltag: Wie wird das Internet of Things unser Leben ändern?Thema: DigitalisierungBegreifen Sie das Internet of Things (IoT): Bauen Sie eine IoT-Applikation und erfahren Sie, was das Internet der Dinge leisten kann. Die Station hilft Ihnen, den Prozess der Systemgestaltung bis hin zum Sensemaking aus der Perspektive der digitalen und gleichzeitig menschenzentrierten Entwicklung besser zu verstehen.Johannes Kepler Universität Linz17:00 - 23:00 -
 AusstellungSicher fliegen: Kann KI die Luftfahrt verbessern?Thema: DigitalisierungDer Flugverkehr nimmt immer mehr zu, wodurch das Flugverkehrsnetz und die beteiligten Personen an ihre Belastungsgrenzen gelangen. Künstliche Intelligenz hilft dabei, das Fliegen sicherer und effizienter zu machen. Wie das geht erfahren Sie an dieser Station.Johannes Kepler Universität Linz17:00 - 23:00
AusstellungSicher fliegen: Kann KI die Luftfahrt verbessern?Thema: DigitalisierungDer Flugverkehr nimmt immer mehr zu, wodurch das Flugverkehrsnetz und die beteiligten Personen an ihre Belastungsgrenzen gelangen. Künstliche Intelligenz hilft dabei, das Fliegen sicherer und effizienter zu machen. Wie das geht erfahren Sie an dieser Station.Johannes Kepler Universität Linz17:00 - 23:00 -
 MitmachstationKampf den Robotern: Können Sie NED 2 schlagen?Thema: DigitalisierungSie halten Tic-Tac-Toe für ein einfaches Spiel? Dann stellen Sie sich Ihrem Herausforderer: dem Roboter NED 2. Viel Glück!Johannes Kepler Universität Linz17:00 - 23:00
MitmachstationKampf den Robotern: Können Sie NED 2 schlagen?Thema: DigitalisierungSie halten Tic-Tac-Toe für ein einfaches Spiel? Dann stellen Sie sich Ihrem Herausforderer: dem Roboter NED 2. Viel Glück!Johannes Kepler Universität Linz17:00 - 23:00 -
 MitmachstationWie verändert KI die Rolle des Menschen insoziotechnischen Systemen?Thema: DigitalisierungDie KI verändert gerade unsere Gesellschaft und damit auch die Wirtschaft. Die Wirtschaftsinformatik stellt sich die Frage: Ist KI nur eine Technologie oder beeinflusst ihre Anwendung langfristig auch die Stellung des Menschen im unternehmerischen Kontext? Finden Sie es heraus!Johannes Kepler Universität Linz17:00 - 23:00
MitmachstationWie verändert KI die Rolle des Menschen insoziotechnischen Systemen?Thema: DigitalisierungDie KI verändert gerade unsere Gesellschaft und damit auch die Wirtschaft. Die Wirtschaftsinformatik stellt sich die Frage: Ist KI nur eine Technologie oder beeinflusst ihre Anwendung langfristig auch die Stellung des Menschen im unternehmerischen Kontext? Finden Sie es heraus!Johannes Kepler Universität Linz17:00 - 23:00 -
 Experiment / VorführungWie kann uns Mathematik vor Hochwasser schützen?Thema: Digitalisierung GesellschaftIn den letzten Jahren hat die Anzahl von Hochwasser-Katastrophen massiv zugenommen und zu enormen Schäden geführt. Aber reicht es in Zukunft, Sandsäcke zu stapeln? Was sind die besten Standorte für solche Schutzmaßnahmen, um möglichst viele Menschen und Gebäude zu sichern? Diese Frage wird an dieser Station mit mathematischen Modellen untersucht.Johannes Kepler Universität Linz17:00 - 23:00
Experiment / VorführungWie kann uns Mathematik vor Hochwasser schützen?Thema: Digitalisierung GesellschaftIn den letzten Jahren hat die Anzahl von Hochwasser-Katastrophen massiv zugenommen und zu enormen Schäden geführt. Aber reicht es in Zukunft, Sandsäcke zu stapeln? Was sind die besten Standorte für solche Schutzmaßnahmen, um möglichst viele Menschen und Gebäude zu sichern? Diese Frage wird an dieser Station mit mathematischen Modellen untersucht.Johannes Kepler Universität Linz17:00 - 23:00 -
 Experiment / VorführungQuantenforschung: Kann Licht Daten transportieren?Thema: Naturwissenschaften TechnikWie sichern wir Daten in der Welt von morgen? Quantenlicht liefert die Antworten. Die JKU öffnet ihre Labortüren und zeigt, wie winzige Nanostrukturen die Grundlage für Quantenkryptographie und ultraschnelle optische Kommunikation bilden. Erleben Sie Forschung live, entdecken Sie anschauliche Demonstrationen und sprechen Sie mit den Expertinnen und Experten, die diese Zukunft mitgestalten.Johannes Kepler Universität Linz17:00 - 23:00
Experiment / VorführungQuantenforschung: Kann Licht Daten transportieren?Thema: Naturwissenschaften TechnikWie sichern wir Daten in der Welt von morgen? Quantenlicht liefert die Antworten. Die JKU öffnet ihre Labortüren und zeigt, wie winzige Nanostrukturen die Grundlage für Quantenkryptographie und ultraschnelle optische Kommunikation bilden. Erleben Sie Forschung live, entdecken Sie anschauliche Demonstrationen und sprechen Sie mit den Expertinnen und Experten, die diese Zukunft mitgestalten.Johannes Kepler Universität Linz17:00 - 23:00 -
 MitmachstationVerjüngungskur: Wie wird alter Kunststoff wieder neu?Thema: Technik UmweltWie wird aus einer alten Verpackung wieder eine neue Verpackung? Testen Sie Ihr Wissen im interaktiven Quiz und Sortierspiel: Welche Verpackungen sind recycelbar? Wo gehört was hinein? Eine Station für Groß und Klein – und wer weiß, vielleicht gewinnen Sie ja sogar einen Preis!Johannes Kepler Universität Linz17:00 - 23:00
MitmachstationVerjüngungskur: Wie wird alter Kunststoff wieder neu?Thema: Technik UmweltWie wird aus einer alten Verpackung wieder eine neue Verpackung? Testen Sie Ihr Wissen im interaktiven Quiz und Sortierspiel: Welche Verpackungen sind recycelbar? Wo gehört was hinein? Eine Station für Groß und Klein – und wer weiß, vielleicht gewinnen Sie ja sogar einen Preis!Johannes Kepler Universität Linz17:00 - 23:00 -
 MitmachstationKunststoff im Wandel - schafft Wissen Kreislauf?Thema: Digitalisierung TechnikDiese interaktive Station zeigt, wie nachhaltig verschiedene Materialien sind. Machen Sie mit und gewinnen Sie Einblicke in Anwendung und Wiederverwertung von Kunststoffen. Lernen Sie, was das Prinzip „Reduce, Reuse, Recycle“ für unsere Zukunft bedeutet und testen Sie Ihr Wissen über nachhaltige Kunststoffe bei einem Gewinnspiel.Johannes Kepler Universität Linz17:00 - 23:00
MitmachstationKunststoff im Wandel - schafft Wissen Kreislauf?Thema: Digitalisierung TechnikDiese interaktive Station zeigt, wie nachhaltig verschiedene Materialien sind. Machen Sie mit und gewinnen Sie Einblicke in Anwendung und Wiederverwertung von Kunststoffen. Lernen Sie, was das Prinzip „Reduce, Reuse, Recycle“ für unsere Zukunft bedeutet und testen Sie Ihr Wissen über nachhaltige Kunststoffe bei einem Gewinnspiel.Johannes Kepler Universität Linz17:00 - 23:00 -
 Experiment / VorführungWie sieht die Fabrik der Zukunft aus?Thema: TechnikTauchen Sie ein in das 5G/6G-Testbed von Silicon Austria Labs: Ein mobiler Roboter überträgt Live-Videos, fährt durch die Halle und arbeitet mit einem intelligenten Roboterarm zusammen. Können die beiden ein Werkstück übergeben, wenn es auf jeden Zentimeter ankommt? Erleben Sie hautnah, wie Roboter miteinander kommunizieren und Industrie 5.0 Wirklichkeit wird.Silicon Austria Labs GmbH17:00 - 23:00
Experiment / VorführungWie sieht die Fabrik der Zukunft aus?Thema: TechnikTauchen Sie ein in das 5G/6G-Testbed von Silicon Austria Labs: Ein mobiler Roboter überträgt Live-Videos, fährt durch die Halle und arbeitet mit einem intelligenten Roboterarm zusammen. Können die beiden ein Werkstück übergeben, wenn es auf jeden Zentimeter ankommt? Erleben Sie hautnah, wie Roboter miteinander kommunizieren und Industrie 5.0 Wirklichkeit wird.Silicon Austria Labs GmbH17:00 - 23:00 -
 ShowprogrammKepler’s Traum. Die erste Reise zum Mond?Thema: Kultur NaturwissenschaftenTauchen Sie ein in eine außergewöhnliche Verbindung von Wissenschaft, Literatur und Musik: Die bekannte Schauspielerin Larissa Fuchs erweckt Johannes Keplers visionäres Werk „Somnium“ mit ihrer Lesung zum Leben. Begleitet von stimmungsvoller Musik (Georg Graf) entfaltet sich Keplers frühe Science-Fiction als sinnliches Erlebnis - poetisch, klug und überraschend aktuell.Johannes Kepler Universität Linz20:30 - 20:30 (Anmeldung erforderlich)
ShowprogrammKepler’s Traum. Die erste Reise zum Mond?Thema: Kultur NaturwissenschaftenTauchen Sie ein in eine außergewöhnliche Verbindung von Wissenschaft, Literatur und Musik: Die bekannte Schauspielerin Larissa Fuchs erweckt Johannes Keplers visionäres Werk „Somnium“ mit ihrer Lesung zum Leben. Begleitet von stimmungsvoller Musik (Georg Graf) entfaltet sich Keplers frühe Science-Fiction als sinnliches Erlebnis - poetisch, klug und überraschend aktuell.Johannes Kepler Universität Linz20:30 - 20:30 (Anmeldung erforderlich) -
 Experiment / VorführungFröhliche Eiszeit: Wissen Sie, wie gut Stickstoff schmeckt?Thema: NaturwissenschaftenEs ist die alte Streitfrage: Was schmeckt besser – Schoko,- Erdbeer- oder Vanilleeis? Am besten probieren Sie an dieser Station alle drei Sorten. Achja, gemacht wird die Leckerei mit Hilfe von Stickstoff. Der ist reichlich vorhanden und mit 78 % der Hauptbestandteil der Luft, die wir atmen. Aber wie macht man aus diesem Element Speiseeis? Wir führen das eiskalt vor – und lassen Sie kosten.Johannes Kepler Universität Linz17:00 - 23:00
Experiment / VorführungFröhliche Eiszeit: Wissen Sie, wie gut Stickstoff schmeckt?Thema: NaturwissenschaftenEs ist die alte Streitfrage: Was schmeckt besser – Schoko,- Erdbeer- oder Vanilleeis? Am besten probieren Sie an dieser Station alle drei Sorten. Achja, gemacht wird die Leckerei mit Hilfe von Stickstoff. Der ist reichlich vorhanden und mit 78 % der Hauptbestandteil der Luft, die wir atmen. Aber wie macht man aus diesem Element Speiseeis? Wir führen das eiskalt vor – und lassen Sie kosten.Johannes Kepler Universität Linz17:00 - 23:00 -
AusstellungEssen aus der Petrischale – kann das schmecken?Thema: NaturwissenschaftenAn der Station soll der Prozess der Protein-Expression veranschaulicht werden. Was das bedeutet? Hier kann man sehen, wie aus einer leeren Petrischale fluoreszierende Proteine auftauchen – und wie man damit Analysen vornehmen kann. Die Besucher:innen können auf spielerische Weise selbst teilnehmen: von Origami bis zum Verkosten von Gelatine. Mahlzeit!Johannes Kepler Universität Linz17:00 - 23:00
AusstellungEssen aus der Petrischale – kann das schmecken?Thema: NaturwissenschaftenAn der Station soll der Prozess der Protein-Expression veranschaulicht werden. Was das bedeutet? Hier kann man sehen, wie aus einer leeren Petrischale fluoreszierende Proteine auftauchen – und wie man damit Analysen vornehmen kann. Die Besucher:innen können auf spielerische Weise selbst teilnehmen: von Origami bis zum Verkosten von Gelatine. Mahlzeit!Johannes Kepler Universität Linz17:00 - 23:00 -
 Experiment / VorführungMond und Mars – welches Material brauchen wir, um im Weltraum zu reisen?Thema: Naturwissenschaften TechnikSchon vor rund 400 Jahren träumte Johannes Kepler, Namensgeber unserer Universität, von Reisen zum Mond. Heute ist das möglich – auch dank chemischer und polymerer Materialien und Kunststoffe. An dieser Station erfahren Sie, warum diese Stoffe unverzichtbar sind, wenn wir zum Mond oder Mars fliegen wollen.Johannes Kepler Universität Linz17:00 - 23:00
Experiment / VorführungMond und Mars – welches Material brauchen wir, um im Weltraum zu reisen?Thema: Naturwissenschaften TechnikSchon vor rund 400 Jahren träumte Johannes Kepler, Namensgeber unserer Universität, von Reisen zum Mond. Heute ist das möglich – auch dank chemischer und polymerer Materialien und Kunststoffe. An dieser Station erfahren Sie, warum diese Stoffe unverzichtbar sind, wenn wir zum Mond oder Mars fliegen wollen.Johannes Kepler Universität Linz17:00 - 23:00 -
 Experiment / VorführungWas ist Katalyse und warum könnten wir ohne sie nicht leben?Thema: Naturwissenschaften UmweltDie katalytischen Reaktionen spielen eine extrem wichtige Rolle in der Natur und unserem modernen Leben. Von der Photosynthese über die Bereitstellung ausreichender Mengen an Düngemittel, vom Funktionieren unseres Körpers bis zum Handy - Katalyse ist allgegenwärtig. Sie glauben das nicht? An dieser Station erleben Sie Experimente, die Sie von der Bedeutung der Katalyse überzeugen werden!Johannes Kepler Universität Linz17:00 - 23:00
Experiment / VorführungWas ist Katalyse und warum könnten wir ohne sie nicht leben?Thema: Naturwissenschaften UmweltDie katalytischen Reaktionen spielen eine extrem wichtige Rolle in der Natur und unserem modernen Leben. Von der Photosynthese über die Bereitstellung ausreichender Mengen an Düngemittel, vom Funktionieren unseres Körpers bis zum Handy - Katalyse ist allgegenwärtig. Sie glauben das nicht? An dieser Station erleben Sie Experimente, die Sie von der Bedeutung der Katalyse überzeugen werden!Johannes Kepler Universität Linz17:00 - 23:00 -
 WorkshopWie lange halten organische Solarzellen? Wie funktionieren organische Solarzellen?Thema: EnergieAn dieser Station erforschen Sie Stabilitäts- und Degradationsprozesse organischer Solarzellen. Mithilfe modernster Spektroskopie & Materialanalyse erfahren Sie, wie Wissenschaftler:innen daran arbeiten, langlebige &hocheffiziente Solarzellen herzustellen. Weiters sehen Sie auch, wie Forscher:innen die molekularen Prozesse untersuchen, welche zum Abbau führen - wobei der Schwerpunkt insbesondere auf NFA* liegt.Johannes Kepler Universität Linz17:00 - 23:00
WorkshopWie lange halten organische Solarzellen? Wie funktionieren organische Solarzellen?Thema: EnergieAn dieser Station erforschen Sie Stabilitäts- und Degradationsprozesse organischer Solarzellen. Mithilfe modernster Spektroskopie & Materialanalyse erfahren Sie, wie Wissenschaftler:innen daran arbeiten, langlebige &hocheffiziente Solarzellen herzustellen. Weiters sehen Sie auch, wie Forscher:innen die molekularen Prozesse untersuchen, welche zum Abbau führen - wobei der Schwerpunkt insbesondere auf NFA* liegt.Johannes Kepler Universität Linz17:00 - 23:00 -
 Experiment / VorführungEwig haltbar und gesund: Was ist drin im Honig?Thema: Naturwissenschaften UmweltHonig ist nicht gleich Honig: Um die Reinheit von Honig zu analysieren, verwenden wir Magnetresonanzspektroskopie (NMR). Mit dieser Methode können die verschiedenen Inhaltsstoffe erkannt werden. Finden Sie heraus, was wirklich in Ihrem Honigbrot steckt!Johannes Kepler Universität Linz17:00 - 23:00
Experiment / VorführungEwig haltbar und gesund: Was ist drin im Honig?Thema: Naturwissenschaften UmweltHonig ist nicht gleich Honig: Um die Reinheit von Honig zu analysieren, verwenden wir Magnetresonanzspektroskopie (NMR). Mit dieser Methode können die verschiedenen Inhaltsstoffe erkannt werden. Finden Sie heraus, was wirklich in Ihrem Honigbrot steckt!Johannes Kepler Universität Linz17:00 - 23:00 -
 AusstellungUnglaublich vielfältig: Was hat Verfahrenstechnik mit meinem Leben zu tun?Thema: TechnikVerfahrenstechnik, was ist das? Sie werden überrascht sein: Von Abwasserreinigung über Batterierecycling bis zu Grundlagenforschung werden die vielfältigen Anwendungsbereiche präsentiert und anschaulich gemacht. Kleine Experimente bereichern den Blick hinter die Verfahrenstechnik.Johannes Kepler Universität Linz17:00 - 23:00
AusstellungUnglaublich vielfältig: Was hat Verfahrenstechnik mit meinem Leben zu tun?Thema: TechnikVerfahrenstechnik, was ist das? Sie werden überrascht sein: Von Abwasserreinigung über Batterierecycling bis zu Grundlagenforschung werden die vielfältigen Anwendungsbereiche präsentiert und anschaulich gemacht. Kleine Experimente bereichern den Blick hinter die Verfahrenstechnik.Johannes Kepler Universität Linz17:00 - 23:00 -
 Experiment / VorführungWie wird aus Pflanzen ein Hightech-Werkstoff der Zukunft?Thema: NaturwissenschaftenLernen Sie den Weg kennen, der von Biomasse zu nachhaltigen Materialien führt. Erfahren Sie, welche Rolle dabei Wasserdampf und Mikroorganismen spielen und lösen Sie spannende Quizfragen. Begreifen Sie, wie Textilien als Heizelemente genutzt werden können.Kompetenzzentrum Holz GmbH17:00 - 23:00
Experiment / VorführungWie wird aus Pflanzen ein Hightech-Werkstoff der Zukunft?Thema: NaturwissenschaftenLernen Sie den Weg kennen, der von Biomasse zu nachhaltigen Materialien führt. Erfahren Sie, welche Rolle dabei Wasserdampf und Mikroorganismen spielen und lösen Sie spannende Quizfragen. Begreifen Sie, wie Textilien als Heizelemente genutzt werden können.Kompetenzzentrum Holz GmbH17:00 - 23:00 -
 MitmachstationUnsichtbares sichtbar machen: Wie hilft dir Physik bei der Schatzsuche?Thema: NaturwissenschaftenDurch Wände sehen? Unmöglich! Oder? Zum Glück stehen uns als Physiker:innen jede Menge Hilfsmittel zur Verfügung, um das Unsichtbare sichtbar zu machen. An dieser Station können Sie entdecken, wie das funktioniert – und dabei sogar einen Schatz finden!Johannes Kepler Universität Linz17:00 - 23:00
MitmachstationUnsichtbares sichtbar machen: Wie hilft dir Physik bei der Schatzsuche?Thema: NaturwissenschaftenDurch Wände sehen? Unmöglich! Oder? Zum Glück stehen uns als Physiker:innen jede Menge Hilfsmittel zur Verfügung, um das Unsichtbare sichtbar zu machen. An dieser Station können Sie entdecken, wie das funktioniert – und dabei sogar einen Schatz finden!Johannes Kepler Universität Linz17:00 - 23:00 -
 MitmachstationWas haben Bubble Tea und Geweberegeneration gemeinsam?Thema: NaturwissenschaftenFasziniert von den platzenden Perlen im Bubble Tea? Zustande kommt der Effekt durch eine chemische Reaktion zwischen Kalzium und Alginsäure, einem Bestandteil von Seetang. Aber Alginsäure kann noch viel mehr: Sie birgt auch Potenzial in der Geweberegeneration. Entdecken Sie die spannende Verbindung zwischen Chemie, Nahrung und Medizin, während Sie Bubble-Tea-Perlen herstellen und auch gleich verkosten.Johannes Kepler Universität Linz17:00 - 23:00
MitmachstationWas haben Bubble Tea und Geweberegeneration gemeinsam?Thema: NaturwissenschaftenFasziniert von den platzenden Perlen im Bubble Tea? Zustande kommt der Effekt durch eine chemische Reaktion zwischen Kalzium und Alginsäure, einem Bestandteil von Seetang. Aber Alginsäure kann noch viel mehr: Sie birgt auch Potenzial in der Geweberegeneration. Entdecken Sie die spannende Verbindung zwischen Chemie, Nahrung und Medizin, während Sie Bubble-Tea-Perlen herstellen und auch gleich verkosten.Johannes Kepler Universität Linz17:00 - 23:00 -
 Experiment / VorführungSpuren im Nebel - kann man Radioaktivität sehen?Thema: NaturwissenschaftenNatürliche Radioaktivität ist allgegenwärtig und umgibt uns täglich. Dazu kommt die von Menschen gemachte Radioaktivität mit all ihrem Nutzen und ihren Gefahren. In einer Nebelkammer können Sie hier die Spuren der radioaktiven Teilchen sehen und sogar verschiedene Arten voneinander unterscheiden. Machen Sie mit und werfen Sie einen Blick auf die natürliche Hintergrundstrahlung, die uns alle umgibt.Johannes Kepler Universität Linz17:00 - 23:00
Experiment / VorführungSpuren im Nebel - kann man Radioaktivität sehen?Thema: NaturwissenschaftenNatürliche Radioaktivität ist allgegenwärtig und umgibt uns täglich. Dazu kommt die von Menschen gemachte Radioaktivität mit all ihrem Nutzen und ihren Gefahren. In einer Nebelkammer können Sie hier die Spuren der radioaktiven Teilchen sehen und sogar verschiedene Arten voneinander unterscheiden. Machen Sie mit und werfen Sie einen Blick auf die natürliche Hintergrundstrahlung, die uns alle umgibt.Johannes Kepler Universität Linz17:00 - 23:00 -
 Experiment / VorführungBuntes Wissen: Was sind eigentlich Licht und Farbe?Thema: NaturwissenschaftenOhne Licht sehen wir nichts. Es ist dunkel oder besser: schwarz. Lampen und die Sonne leuchten hell und (meist) weiß. Wieso erscheinen dann Gegenstände farbig, wenn sie das Licht reflektieren? Und – was ist eigentlich Farbe? An dieser Station ist eines sicher: Ihnen wird ein Licht aufgehen!Johannes Kepler Universität Linz17:00 - 23:00
Experiment / VorführungBuntes Wissen: Was sind eigentlich Licht und Farbe?Thema: NaturwissenschaftenOhne Licht sehen wir nichts. Es ist dunkel oder besser: schwarz. Lampen und die Sonne leuchten hell und (meist) weiß. Wieso erscheinen dann Gegenstände farbig, wenn sie das Licht reflektieren? Und – was ist eigentlich Farbe? An dieser Station ist eines sicher: Ihnen wird ein Licht aufgehen!Johannes Kepler Universität Linz17:00 - 23:00 -
 Experiment / VorführungWas kann der Laser, was normale Lichtquellen nicht können?Thema: NaturwissenschaftenMit Licht lassen sich die kleinsten Dinge und die Weiten des Universums wie auch Gravitationswellen vermessen, Oberflächen bearbeiten, chemische Zusammensetzungen ermitteln und noch vieles mehr. Forscher:innen verwenden dazu Laserlicht. Was kann der Laser, was normales Licht nicht kann? Wie funktioniert ein Laser? Das werden Sie an unserer Station erfahren.Johannes Kepler Universität Linz17:00 - 23:00
Experiment / VorführungWas kann der Laser, was normale Lichtquellen nicht können?Thema: NaturwissenschaftenMit Licht lassen sich die kleinsten Dinge und die Weiten des Universums wie auch Gravitationswellen vermessen, Oberflächen bearbeiten, chemische Zusammensetzungen ermitteln und noch vieles mehr. Forscher:innen verwenden dazu Laserlicht. Was kann der Laser, was normales Licht nicht kann? Wie funktioniert ein Laser? Das werden Sie an unserer Station erfahren.Johannes Kepler Universität Linz17:00 - 23:00 -
 Experiment / VorführungAlles im grünen Bereich: Wie funktioniert Photosynthese?Thema: Energie NaturwissenschaftenEin Mann steht mit einem Glas Wasser in der Sonne und wartet darauf, dass Zucker und Sauerstoff entstehen. Da kann er schütteln und warten, wie er will – es klappt nicht. Was also machen Pflanzen anders? Ein Geheimnis liegt im photoaktiven Pigment Chlorophyll. An dieser Station werden Chlorophylle aus Blättern entnommen und zum Leuchten gebracht und die Sauerstoffbildung in Blättern nachgewiesen.Johannes Kepler Universität Linz17:00 - 23:00
Experiment / VorführungAlles im grünen Bereich: Wie funktioniert Photosynthese?Thema: Energie NaturwissenschaftenEin Mann steht mit einem Glas Wasser in der Sonne und wartet darauf, dass Zucker und Sauerstoff entstehen. Da kann er schütteln und warten, wie er will – es klappt nicht. Was also machen Pflanzen anders? Ein Geheimnis liegt im photoaktiven Pigment Chlorophyll. An dieser Station werden Chlorophylle aus Blättern entnommen und zum Leuchten gebracht und die Sauerstoffbildung in Blättern nachgewiesen.Johannes Kepler Universität Linz17:00 - 23:00 -
 Experiment / VorführungKlein, kleiner, Atom: Wie beeinflussen die kleinsten Teilchen unsere Welt?Thema: NaturwissenschaftenWarum sind Elektronen so unsozial? Und wie entsteht Magnetisierung? Was passiert, wenn man nahe beim absoluten Temperaturnullpunkt ankommt? Diesen Fragen wird mit 3D-Brillen, Experimenten wie Simulationen auf Atom-Niveau und einem Physik-Bilderquiz auf den Grund gegangen.Johannes Kepler Universität Linz17:00 - 23:00
Experiment / VorführungKlein, kleiner, Atom: Wie beeinflussen die kleinsten Teilchen unsere Welt?Thema: NaturwissenschaftenWarum sind Elektronen so unsozial? Und wie entsteht Magnetisierung? Was passiert, wenn man nahe beim absoluten Temperaturnullpunkt ankommt? Diesen Fragen wird mit 3D-Brillen, Experimenten wie Simulationen auf Atom-Niveau und einem Physik-Bilderquiz auf den Grund gegangen.Johannes Kepler Universität Linz17:00 - 23:00 -
 FührungCleveres Blech: Wie schützt modernes Autoblech die Passagier:innen?Thema: Naturwissenschaften TechnikWenn weiches Stahlblech blitzschnell hart wird und so Insass:innen bei Autounfällen schützt, oder wenn spezielle Beschichtungen dem Rost wirksam Einhalt gebieten, dann sind dafür Prozesse im Material des Autos verantwortlich. Schauen Sie sich diese Vorgänge genauer an und erfahren Sie, wie wandelbar Materialien sein können!Johannes Kepler Universität Linz17:00 - 23:00
FührungCleveres Blech: Wie schützt modernes Autoblech die Passagier:innen?Thema: Naturwissenschaften TechnikWenn weiches Stahlblech blitzschnell hart wird und so Insass:innen bei Autounfällen schützt, oder wenn spezielle Beschichtungen dem Rost wirksam Einhalt gebieten, dann sind dafür Prozesse im Material des Autos verantwortlich. Schauen Sie sich diese Vorgänge genauer an und erfahren Sie, wie wandelbar Materialien sein können!Johannes Kepler Universität Linz17:00 - 23:00 -
 ShowprogrammÜberraschung! Eine Mathe-Party?Thema: KulturJo & Jo feiern Geburtstag. Aber wie viele Kerzen gehören eigentlich auf die Geburtstagstorte der Zwillinge? Und wie kann diese Torte am besten für so viele Gäste geteilt werden? Und was hat die Torte mit dem geheimnisvollen Pi zu tun? Mit diesen einfachen Fragen beginnt eine Reise auf den Spuren der Mathematik…Johannes Kepler Universität Linz18:00 - 18:00 (Anmeldung erforderlich)
ShowprogrammÜberraschung! Eine Mathe-Party?Thema: KulturJo & Jo feiern Geburtstag. Aber wie viele Kerzen gehören eigentlich auf die Geburtstagstorte der Zwillinge? Und wie kann diese Torte am besten für so viele Gäste geteilt werden? Und was hat die Torte mit dem geheimnisvollen Pi zu tun? Mit diesen einfachen Fragen beginnt eine Reise auf den Spuren der Mathematik…Johannes Kepler Universität Linz18:00 - 18:00 (Anmeldung erforderlich) -
 Experiment / VorführungWarum entwickeln wir Hydraulik?Thema: TechnikAm Beispiel unseres Kompaktbaggers erklären wir, wie Mobilhydraulik heute funktioniert. Wir diskutieren mit Ihnen, wie sie in Zukunft funktionieren soll - CO2-neutral, effizient, entsprechend den neuen Anforderungen der Baustelle. Also: raus mit den Drosselventilen, wir entwickeln Pumpen zur direkten Steuerung der Hydraulikzylinder.Johannes Kepler Universität Linz17:00 - 23:00
Experiment / VorführungWarum entwickeln wir Hydraulik?Thema: TechnikAm Beispiel unseres Kompaktbaggers erklären wir, wie Mobilhydraulik heute funktioniert. Wir diskutieren mit Ihnen, wie sie in Zukunft funktionieren soll - CO2-neutral, effizient, entsprechend den neuen Anforderungen der Baustelle. Also: raus mit den Drosselventilen, wir entwickeln Pumpen zur direkten Steuerung der Hydraulikzylinder.Johannes Kepler Universität Linz17:00 - 23:00 -
 MitmachstationDer KI-Chatbot-Hype – wie klug sind Künstliche Intelligenzen?Thema: DigitalisierungErleben Sie eine interaktive Mitmachstation rund um KI-Chatbots! Stellen Sie Fragen und entdecken Sie, wie unterschiedlich Künstliche Intelligenzen reagieren können. Tauchen Sie ein in die Welt des KI-Trainings und finden Sie heraus, wie ChatGPT & Co zu ihren Antworten kommen - und warum es sich lohnt, immer genau hinzusehen.Johannes Kepler Universität Linz17:00 - 23:00
MitmachstationDer KI-Chatbot-Hype – wie klug sind Künstliche Intelligenzen?Thema: DigitalisierungErleben Sie eine interaktive Mitmachstation rund um KI-Chatbots! Stellen Sie Fragen und entdecken Sie, wie unterschiedlich Künstliche Intelligenzen reagieren können. Tauchen Sie ein in die Welt des KI-Trainings und finden Sie heraus, wie ChatGPT & Co zu ihren Antworten kommen - und warum es sich lohnt, immer genau hinzusehen.Johannes Kepler Universität Linz17:00 - 23:00 -
 Experiment / VorführungCoffee to go: Wer ist der oder die schnellste Kellner:in der Welt?Thema: DigitalisierungSie wollen wissen, wozu Industrieroboter in der Lage sind? Begegnen Sie in einer spektakulären Live-Demonstration dem schnellsten Robo-Kellner der Welt, der Kaffee auf einem Tablett sogar durch die Luft schleudern kann, ohne etwas zu verschütten. Außerdem können Sie selbst einen Roboterarm ansteuern und versuchen, eine Kaffeetasse ohne direkten Sichtkontakt zu bewegen.Johannes Kepler Universität Linz17:00 - 23:00
Experiment / VorführungCoffee to go: Wer ist der oder die schnellste Kellner:in der Welt?Thema: DigitalisierungSie wollen wissen, wozu Industrieroboter in der Lage sind? Begegnen Sie in einer spektakulären Live-Demonstration dem schnellsten Robo-Kellner der Welt, der Kaffee auf einem Tablett sogar durch die Luft schleudern kann, ohne etwas zu verschütten. Außerdem können Sie selbst einen Roboterarm ansteuern und versuchen, eine Kaffeetasse ohne direkten Sichtkontakt zu bewegen.Johannes Kepler Universität Linz17:00 - 23:00 -
 Experiment / VorführungWas passiert beim Eintauchen ins Wasser?Thema: Naturwissenschaften TechnikHier können Besucher:innen im Detail beobachten, wie der Eintritt verschiedener Objekte ins Wasser abläuft und welche Luftblasen sich dabei ausbilden. Live-Experimente werden mit der Hochgeschwindigkeitskamera aufgenommen und im Anschluss visualisiert und erklärt. Also los, lassen Sie verschiedene Objekte eintauchen – von Kugeln bis zu Vogelmodellen!Johannes Kepler Universität Linz17:00 - 23:00
Experiment / VorführungWas passiert beim Eintauchen ins Wasser?Thema: Naturwissenschaften TechnikHier können Besucher:innen im Detail beobachten, wie der Eintritt verschiedener Objekte ins Wasser abläuft und welche Luftblasen sich dabei ausbilden. Live-Experimente werden mit der Hochgeschwindigkeitskamera aufgenommen und im Anschluss visualisiert und erklärt. Also los, lassen Sie verschiedene Objekte eintauchen – von Kugeln bis zu Vogelmodellen!Johannes Kepler Universität Linz17:00 - 23:00 -
 MitmachstationAlles geht kaputt - Woran liegt das eigentlich?Thema: Digitalisierung TechnikWir zeigen's Ihnen! Moderne Leichtbauteile sind komplexe und hoch optimierte Strukturen, die ihre Funktion trotz unterschiedlichster Belastungen zuverlässig erfüllen müssen. Alle Belastungen vorab zu testen, ist aber aus wirtschaftlichen Gründen nicht möglich. Wie man dennoch mit wenigen Bauteilversuchen Sicherheit garantiert und warum das Bauteil am Ende auch brechen darf, erfahren Sie bei uns.Johannes Kepler Universität Linz17:00 - 23:00
MitmachstationAlles geht kaputt - Woran liegt das eigentlich?Thema: Digitalisierung TechnikWir zeigen's Ihnen! Moderne Leichtbauteile sind komplexe und hoch optimierte Strukturen, die ihre Funktion trotz unterschiedlichster Belastungen zuverlässig erfüllen müssen. Alle Belastungen vorab zu testen, ist aber aus wirtschaftlichen Gründen nicht möglich. Wie man dennoch mit wenigen Bauteilversuchen Sicherheit garantiert und warum das Bauteil am Ende auch brechen darf, erfahren Sie bei uns.Johannes Kepler Universität Linz17:00 - 23:00 -
 Experiment / VorführungWie können Glasfasern zuhören?Thema: DigitalisierungGlasfasern bringen nicht nur blitzschnelles Internet in Ihr Zuhause, sie können auch zuhören! In der Glasfaser rast Licht wie ein unsichtbares Ohr und fängt jedes Klatschen, Sprechen oder Stampfen ein. Machen Sie selbst Lärm, sprechen Sie ins Licht oder klatschen Sie in die Hände und sehen Sie live, wie Geräusche sichtbar werden. Welche Töne in Ihrem Alltag könnten Glasfasern hören?Johannes Kepler Universität Linz17:00 - 23:00
Experiment / VorführungWie können Glasfasern zuhören?Thema: DigitalisierungGlasfasern bringen nicht nur blitzschnelles Internet in Ihr Zuhause, sie können auch zuhören! In der Glasfaser rast Licht wie ein unsichtbares Ohr und fängt jedes Klatschen, Sprechen oder Stampfen ein. Machen Sie selbst Lärm, sprechen Sie ins Licht oder klatschen Sie in die Hände und sehen Sie live, wie Geräusche sichtbar werden. Welche Töne in Ihrem Alltag könnten Glasfasern hören?Johannes Kepler Universität Linz17:00 - 23:00 -
 Experiment / VorführungKleine und große Helfer:innen - Wie bewegen elektrische Maschinen die Welt?Thema: DigitalisierungElektrische Maschinen treiben unsere Welt an - oft unsichtbar, aber unverzichtbar. Wie funktioniert der Antrieb eines Elektroautos? Warum laufen Textilmaschinen mit mehr als 200.000 Umdrehungen pro Minute? Und wie kann Magnetlagertechnik sogar Herzen am Schlagen halten? Tauchen Sie mit uns in die faszinierende Welt der elektrischen Antriebstechnik ein.Johannes Kepler Universität Linz17:00 - 23:00
Experiment / VorführungKleine und große Helfer:innen - Wie bewegen elektrische Maschinen die Welt?Thema: DigitalisierungElektrische Maschinen treiben unsere Welt an - oft unsichtbar, aber unverzichtbar. Wie funktioniert der Antrieb eines Elektroautos? Warum laufen Textilmaschinen mit mehr als 200.000 Umdrehungen pro Minute? Und wie kann Magnetlagertechnik sogar Herzen am Schlagen halten? Tauchen Sie mit uns in die faszinierende Welt der elektrischen Antriebstechnik ein.Johannes Kepler Universität Linz17:00 - 23:00 -
 MitmachstationEntwicklung und Fertigung: Wie baut man einen Rennwagen?Thema: Gesellschaft TechnikDas Rennen beginnt! Das JKU Racing Team gibt Ihnen einen Einblick in die Entwicklung und den Bau eines elektrisch angetriebenen Rennwagens. Österreichs jüngstes Formula-Student-Team lässt Sie eintauchen in die Welt des Rennsports – und der Forschung.Johannes Kepler Universität Linz17:00 - 23:00
MitmachstationEntwicklung und Fertigung: Wie baut man einen Rennwagen?Thema: Gesellschaft TechnikDas Rennen beginnt! Das JKU Racing Team gibt Ihnen einen Einblick in die Entwicklung und den Bau eines elektrisch angetriebenen Rennwagens. Österreichs jüngstes Formula-Student-Team lässt Sie eintauchen in die Welt des Rennsports – und der Forschung.Johannes Kepler Universität Linz17:00 - 23:00 -
 AusstellungEnergie in Bewegung: Wie funktionieren intelligente elektrische Antriebe?Thema: Energie TechnikBeim Linz Center of Mechatronics (LCM) entdecken Besucher:innen, wie elektrische Antriebe der Zukunft entwickelt und zum Leben erweckt werden. Die Station zeigt, wie Forschung buchstäblich in Bewegung gerät – mit spannenden Einblicken in aktuelle Projekte wie Hochleistungsantriebe für Brennstoffzellen oder das innovative eVSP-System, eine moderne Weiterentwicklung des Voith-Schneider-Propellers.Linz Center of Mechatronics GmbH17:00 - 23:00
AusstellungEnergie in Bewegung: Wie funktionieren intelligente elektrische Antriebe?Thema: Energie TechnikBeim Linz Center of Mechatronics (LCM) entdecken Besucher:innen, wie elektrische Antriebe der Zukunft entwickelt und zum Leben erweckt werden. Die Station zeigt, wie Forschung buchstäblich in Bewegung gerät – mit spannenden Einblicken in aktuelle Projekte wie Hochleistungsantriebe für Brennstoffzellen oder das innovative eVSP-System, eine moderne Weiterentwicklung des Voith-Schneider-Propellers.Linz Center of Mechatronics GmbH17:00 - 23:00 -
 AusstellungWie funktioniert multimediales Jus-Studieren?Thema: GesellschaftDas Institut für Multimediale Linzer Rechtsstudien betreut das in Österreich einzigartige Multimedia-Diplomstudium der Rechtswissenschaften der JKU Linz. Dieses Studium nutzt die moderne Technik, um ein zeit- und ortsunabhängiges Jus-Studieren mit größtmöglicher Lernautonomie zu ermöglichen. Probieren Sie die multimedialen Lernmaterialen an der Station aus und sehen Sie sich Publikationen des Instituts an!Johannes Kepler Universität Linz17:00 - 23:00
AusstellungWie funktioniert multimediales Jus-Studieren?Thema: GesellschaftDas Institut für Multimediale Linzer Rechtsstudien betreut das in Österreich einzigartige Multimedia-Diplomstudium der Rechtswissenschaften der JKU Linz. Dieses Studium nutzt die moderne Technik, um ein zeit- und ortsunabhängiges Jus-Studieren mit größtmöglicher Lernautonomie zu ermöglichen. Probieren Sie die multimedialen Lernmaterialen an der Station aus und sehen Sie sich Publikationen des Instituts an!Johannes Kepler Universität Linz17:00 - 23:00 -
 MitmachstationKann Recht die Welt gerechter machen?Thema: GesellschaftIst Recht immer gerecht? Erfahren Sie hier, wie die Rechte behinderter Menschen geschützt werden, was es für einen fairen Einsatz von Künstlicher Intelligenz braucht, wie wir rechtliches Wissen durch körperliche Erfahrungen erlernen können und wie der Schutz vor häuslicher Gewalt in der Praxis funktioniert. Außerdem können Sie sich an einem wissenschaftlichen Podcast auch selbst beteiligen.Johannes Kepler Universität Linz17:00 - 23:00
MitmachstationKann Recht die Welt gerechter machen?Thema: GesellschaftIst Recht immer gerecht? Erfahren Sie hier, wie die Rechte behinderter Menschen geschützt werden, was es für einen fairen Einsatz von Künstlicher Intelligenz braucht, wie wir rechtliches Wissen durch körperliche Erfahrungen erlernen können und wie der Schutz vor häuslicher Gewalt in der Praxis funktioniert. Außerdem können Sie sich an einem wissenschaftlichen Podcast auch selbst beteiligen.Johannes Kepler Universität Linz17:00 - 23:00 -
 AusstellungPreise für CO₂ – hilft das wirklich dem Klimaschutz?Thema: UmweltStaaten setzen im Kampf gegen den Klimawandel zunehmend auf CO₂-Steuern und Emissionshandelssysteme. An dieser Station wird gezeigt, wie diese Instrumente funktionieren, welche Wirkung sie auf Wirtschaft und Gesellschaft haben und wo ihre Grenzen liegen. Besucher:innen sind eingeladen, sich mit der Rolle der CO₂-Bepreisung im Klimaschutz auseinanderzusetzen und mitzudiskutieren.Johannes Kepler Universität Linz17:00 - 23:00
AusstellungPreise für CO₂ – hilft das wirklich dem Klimaschutz?Thema: UmweltStaaten setzen im Kampf gegen den Klimawandel zunehmend auf CO₂-Steuern und Emissionshandelssysteme. An dieser Station wird gezeigt, wie diese Instrumente funktionieren, welche Wirkung sie auf Wirtschaft und Gesellschaft haben und wo ihre Grenzen liegen. Besucher:innen sind eingeladen, sich mit der Rolle der CO₂-Bepreisung im Klimaschutz auseinanderzusetzen und mitzudiskutieren.Johannes Kepler Universität Linz17:00 - 23:00 -
 MitmachstationAlles, was recht ist: Wie schmeckt Nachhaltigkeit?Thema: UmweltHier können Sie Nachhaltigkeit erleben, lachen und mitreden: Entdecken Sie spannende Cartoons zu Umweltthemen und ein informatives Video zur Ausbildung im Umweltrecht. Für Kinder gibt’s zudem eine kreative Malecke zum Thema "Superheld:innen retten die Welt". Dazu genießen Groß und Klein Bio-Popcorn und erfrischende Säfte aus regionalem und nachhaltigem Obstbau. Viel Spaß und guten Appetit!Johannes Kepler Universität Linz17:00 - 23:00
MitmachstationAlles, was recht ist: Wie schmeckt Nachhaltigkeit?Thema: UmweltHier können Sie Nachhaltigkeit erleben, lachen und mitreden: Entdecken Sie spannende Cartoons zu Umweltthemen und ein informatives Video zur Ausbildung im Umweltrecht. Für Kinder gibt’s zudem eine kreative Malecke zum Thema "Superheld:innen retten die Welt". Dazu genießen Groß und Klein Bio-Popcorn und erfrischende Säfte aus regionalem und nachhaltigem Obstbau. Viel Spaß und guten Appetit!Johannes Kepler Universität Linz17:00 - 23:00 -
 MitmachstationZeug:innen vor Gericht: Wem können wir glauben?Thema: Gesellschaft WirtschaftFünf Zeug:innen vor Gericht, fünf verschiedene Aussagen… Wem sollen die Richter:innen glauben? Hier können Sie selbst anhand von Videoausschnitten Zeug:innen-Aussagen beurteilen und sie bewerten – und erfahren, welche Faktoren Ihre Wahrnehmung und Urteile beeinflussen.Johannes Kepler Universität Linz17:00 - 23:00
MitmachstationZeug:innen vor Gericht: Wem können wir glauben?Thema: Gesellschaft WirtschaftFünf Zeug:innen vor Gericht, fünf verschiedene Aussagen… Wem sollen die Richter:innen glauben? Hier können Sie selbst anhand von Videoausschnitten Zeug:innen-Aussagen beurteilen und sie bewerten – und erfahren, welche Faktoren Ihre Wahrnehmung und Urteile beeinflussen.Johannes Kepler Universität Linz17:00 - 23:00 -
 MitmachstationAlles im grünen Bereich: Wie kann man mit Quantensensoren Material testen?Thema: Naturwissenschaften TechnikBei der RECENDT erhalten Sie faszinierende Einblicke in moderne Methoden der Materialprüfung. Durch Terahertz-, Wärmewellen oder neuartige Quantensensoren werden Messverfahren präzise und kostengünstig durchgeführt, ohne das Material zu beschädigen. Sie erfahren an dieser Station außerdem, wie vielfältig Ultraschall erzeugt und genutzt werden kann.RECENDT - Research Center for Non-Destructive Testing GmbH17:00 - 23:00
MitmachstationAlles im grünen Bereich: Wie kann man mit Quantensensoren Material testen?Thema: Naturwissenschaften TechnikBei der RECENDT erhalten Sie faszinierende Einblicke in moderne Methoden der Materialprüfung. Durch Terahertz-, Wärmewellen oder neuartige Quantensensoren werden Messverfahren präzise und kostengünstig durchgeführt, ohne das Material zu beschädigen. Sie erfahren an dieser Station außerdem, wie vielfältig Ultraschall erzeugt und genutzt werden kann.RECENDT - Research Center for Non-Destructive Testing GmbH17:00 - 23:00 -
 Mitmachstation[ABGESAGT] Was kann KI?Thema: DigitalisierungIn der KI-Wunderwelt können Besucher:innen die Faszination der Künstlichen Intelligenz erleben und verstehen, wie diese Technologie unsere Welt verändert. Besucher:innen können ihr eigenes Spiel gestalten, das Löten erlernen und spielerisch die faszinierenden Möglichkeiten von KI und moderner Technologie entdecken.Dynatrace Austria GmbH17:00 - 23:00
Mitmachstation[ABGESAGT] Was kann KI?Thema: DigitalisierungIn der KI-Wunderwelt können Besucher:innen die Faszination der Künstlichen Intelligenz erleben und verstehen, wie diese Technologie unsere Welt verändert. Besucher:innen können ihr eigenes Spiel gestalten, das Löten erlernen und spielerisch die faszinierenden Möglichkeiten von KI und moderner Technologie entdecken.Dynatrace Austria GmbH17:00 - 23:00 -
 MitmachstationZukunfts(t)räume: Was wäre, wenn morgen alles möglich wäre?Thema: Gesellschaft UmweltIm Zukunfts(t)raum des LIFT_C entwerfen Besucher:innen Utopien für morgen. Methoden des Monsterwritings laden Jung und Alt ein, sich kreativ mit vier Themenkomplexen auseinanderzusetzen: Wirtschaft, Organisation, globale Warenströme und digitaler Raum. Gemeinsam verschieben wir die Grenzen des Denkbaren und entwickeln kollektive Visionen, die lebendig werden. Welche Zukunft wollen wir erschaffen? Gestalten Sie mit!Johannes Kepler Universität Linz17:00 - 23:00
MitmachstationZukunfts(t)räume: Was wäre, wenn morgen alles möglich wäre?Thema: Gesellschaft UmweltIm Zukunfts(t)raum des LIFT_C entwerfen Besucher:innen Utopien für morgen. Methoden des Monsterwritings laden Jung und Alt ein, sich kreativ mit vier Themenkomplexen auseinanderzusetzen: Wirtschaft, Organisation, globale Warenströme und digitaler Raum. Gemeinsam verschieben wir die Grenzen des Denkbaren und entwickeln kollektive Visionen, die lebendig werden. Welche Zukunft wollen wir erschaffen? Gestalten Sie mit!Johannes Kepler Universität Linz17:00 - 23:00 -
 MitmachstationWie macht Algebra Symmetrien verständlich?Thema: NaturwissenschaftenSymmetrien spielen in vielen Bereichen von Wissenschaft und Technik eine wichtige Rolle. Algebra ist die perfekte Methode, um solche Symmetrien zu beschreiben. Wie das geht, erfahren Sie hier – und können auch gleich selbst damit experimentieren.Johannes Kepler Universität Linz17:00 - 23:00
MitmachstationWie macht Algebra Symmetrien verständlich?Thema: NaturwissenschaftenSymmetrien spielen in vielen Bereichen von Wissenschaft und Technik eine wichtige Rolle. Algebra ist die perfekte Methode, um solche Symmetrien zu beschreiben. Wie das geht, erfahren Sie hier – und können auch gleich selbst damit experimentieren.Johannes Kepler Universität Linz17:00 - 23:00 -
 MitmachstationWie bringt man Ordnung in den Zufall?Thema: Digitalisierung NaturwissenschaftenVom Tumorwachstum bis zur Handy-App: Stochastik steckt überall! Hören Sie drei kurze Vorträge zu Markov-Prozessen, KI-Optimierung und der Modellierung lebenswichtiger Systeme. Sie können auch selbst mitmachen: Verfolgen Sie live Bewegungstracking und eine „Lego Mario“-Gesten-Challenge mit Sensordaten. Erleben Sie, wie KI aus Beschleunigungsmessern Bewegungen erkennt und entdecken Sie die Ordnung im scheinbaren ZufallJohannes Kepler Universität Linz17:00 - 23:00
MitmachstationWie bringt man Ordnung in den Zufall?Thema: Digitalisierung NaturwissenschaftenVom Tumorwachstum bis zur Handy-App: Stochastik steckt überall! Hören Sie drei kurze Vorträge zu Markov-Prozessen, KI-Optimierung und der Modellierung lebenswichtiger Systeme. Sie können auch selbst mitmachen: Verfolgen Sie live Bewegungstracking und eine „Lego Mario“-Gesten-Challenge mit Sensordaten. Erleben Sie, wie KI aus Beschleunigungsmessern Bewegungen erkennt und entdecken Sie die Ordnung im scheinbaren ZufallJohannes Kepler Universität Linz17:00 - 23:00 -
 Experiment / VorführungWie arbeiten autonome KIs in der Produktion sicher mit dem Menschen zusammen?Thema: DigitalisierungWir zeigen, wie Sensorik, Aktuatorik und die KI nahtlos ineinandergreifen, damit Systeme in der Industrie autonom und miteinander (inter-)agieren können. Erleben Sie live, welche Regeln die KI beachten muss, um in der Fabrik von morgen sicher mit uns Menschen zusammenarbeiten zu können!Pro2Future GmbH17:00 - 23:00
Experiment / VorführungWie arbeiten autonome KIs in der Produktion sicher mit dem Menschen zusammen?Thema: DigitalisierungWir zeigen, wie Sensorik, Aktuatorik und die KI nahtlos ineinandergreifen, damit Systeme in der Industrie autonom und miteinander (inter-)agieren können. Erleben Sie live, welche Regeln die KI beachten muss, um in der Fabrik von morgen sicher mit uns Menschen zusammenarbeiten zu können!Pro2Future GmbH17:00 - 23:00 -
 Experiment / VorführungMein Kumpel, der Roboter: Wie werden Maschinen fit für Menschen gemacht?Thema: DigitalisierungHier erleben Sie die Zusammenarbeit zwischen Menschen und Robotern, die darauf ausgelegt ist, Produktionsprozesse zu optimieren. Durch die Verwendung einer Vielzahl von Sensoren und maschinellem Lernen statten wir Roboter mit fortschrittlichen kognitiven Fähigkeiten aus – überzeugen Sie sich selbst!Pro2Future GmbH17:00 - 23:00
Experiment / VorführungMein Kumpel, der Roboter: Wie werden Maschinen fit für Menschen gemacht?Thema: DigitalisierungHier erleben Sie die Zusammenarbeit zwischen Menschen und Robotern, die darauf ausgelegt ist, Produktionsprozesse zu optimieren. Durch die Verwendung einer Vielzahl von Sensoren und maschinellem Lernen statten wir Roboter mit fortschrittlichen kognitiven Fähigkeiten aus – überzeugen Sie sich selbst!Pro2Future GmbH17:00 - 23:00 -
 MitmachstationSind Microchips wirklich intelligent?Thema: Digitalisierung TechnikIm Alltag kaum noch wegzudenken: das Smartphone oder smarte Assistenzsysteme in modernen Autos. Hochminiaturisierte Mikrochip- und Sensor-Systeme, die im Hintergrund die Arbeit verrichten und immer intelligenter werden. Aber wie funktioniert das? Und sind Mikrochips wirklich intelligent? Am Stand für Elektronik und Informationstechnik werden diese Fragen beantwortet.Johannes Kepler Universität Linz17:00 - 23:00
MitmachstationSind Microchips wirklich intelligent?Thema: Digitalisierung TechnikIm Alltag kaum noch wegzudenken: das Smartphone oder smarte Assistenzsysteme in modernen Autos. Hochminiaturisierte Mikrochip- und Sensor-Systeme, die im Hintergrund die Arbeit verrichten und immer intelligenter werden. Aber wie funktioniert das? Und sind Mikrochips wirklich intelligent? Am Stand für Elektronik und Informationstechnik werden diese Fragen beantwortet.Johannes Kepler Universität Linz17:00 - 23:00 -
 MitmachstationForschung und Fortschritt: Woher kommt eigentlich das Geld für Forschung?Thema: GesellschaftStellen Sie sich vor, Sie grübeln über einem Problem. Doch für die Lösung und die Umsetzung brauchen Sie Geld und Ressourcen. So geht es auch Forscher:innen. Machen Sie sich auf die Reise von Forschenden, die Förderungen suchen, stellen Sie einen Förderantrag und erfahren Sie, warum Ihr Steuergeld bei Forschungsförderung gut angelegt ist. Denn: Fortschritt braucht Forschung!Johannes Kepler Universität Linz17:00 - 23:00
MitmachstationForschung und Fortschritt: Woher kommt eigentlich das Geld für Forschung?Thema: GesellschaftStellen Sie sich vor, Sie grübeln über einem Problem. Doch für die Lösung und die Umsetzung brauchen Sie Geld und Ressourcen. So geht es auch Forscher:innen. Machen Sie sich auf die Reise von Forschenden, die Förderungen suchen, stellen Sie einen Förderantrag und erfahren Sie, warum Ihr Steuergeld bei Forschungsförderung gut angelegt ist. Denn: Fortschritt braucht Forschung!Johannes Kepler Universität Linz17:00 - 23:00 -
 MitmachstationNa logisch: Wie denken Computer?Thema: DigitalisierungWie "denkt" ein Computer? Die Antwort liefert uns die Logik. Dabei wird nicht mit Zahlen gerechnet, sondern mit "Wahr" oder "Falsch". Das Rechnen selbst funktioniert ähnlich wie mit Plus, Minus&Mal. Damit können wir auf einfache Weise beschreiben, wie ein Computer rechnet, arbeitet und von bekanntem Wissen neue Fakten ableitet. Lernen Sie praktische Anwendungen der Logik kennen, wie sie an der JKU erforscht werden.Johannes Kepler Universität Linz17:00 - 23:00
MitmachstationNa logisch: Wie denken Computer?Thema: DigitalisierungWie "denkt" ein Computer? Die Antwort liefert uns die Logik. Dabei wird nicht mit Zahlen gerechnet, sondern mit "Wahr" oder "Falsch". Das Rechnen selbst funktioniert ähnlich wie mit Plus, Minus&Mal. Damit können wir auf einfache Weise beschreiben, wie ein Computer rechnet, arbeitet und von bekanntem Wissen neue Fakten ableitet. Lernen Sie praktische Anwendungen der Logik kennen, wie sie an der JKU erforscht werden.Johannes Kepler Universität Linz17:00 - 23:00 -
 Experiment / VorführungProzessoren-Know-how: Kann ich ein Computer werden?Thema: DigitalisierungWarum versteht ein Prozessor nur 0 und 1? Und wie entstehen aus diesen zwei Ziffern Spiele, Fotos oder KI? An dieser Station machen wir mit Ihrer Hilfe den unsichtbaren Teil des Computers sichtbar: Sie werden selbst zum Prozessor und führen ein kleines Programm Schritt für Schritt aus!Johannes Kepler Universität Linz17:00 - 23:00
Experiment / VorführungProzessoren-Know-how: Kann ich ein Computer werden?Thema: DigitalisierungWarum versteht ein Prozessor nur 0 und 1? Und wie entstehen aus diesen zwei Ziffern Spiele, Fotos oder KI? An dieser Station machen wir mit Ihrer Hilfe den unsichtbaren Teil des Computers sichtbar: Sie werden selbst zum Prozessor und führen ein kleines Programm Schritt für Schritt aus!Johannes Kepler Universität Linz17:00 - 23:00 -
 MitmachstationForschung macht Schule: Wie sollen unsere Kinder lernen?Thema: Digitalisierung GesellschaftSind kleinere Klassen wirklich besser? Lernen Kinder mit Tablets mehr? Und was bringt Hausübung tatsächlich? Lernen Sie typische Mythen aus dem Bildungsbereich kennen, vergleichen Sie diese mit aktuellen Forschungsergebnissen und erfahren Sie, warum wissenschaftliche Befunde oft überraschender sind als Schlagzeilen dies vermuten lassen.Johannes Kepler Universität Linz17:00 - 23:00
MitmachstationForschung macht Schule: Wie sollen unsere Kinder lernen?Thema: Digitalisierung GesellschaftSind kleinere Klassen wirklich besser? Lernen Kinder mit Tablets mehr? Und was bringt Hausübung tatsächlich? Lernen Sie typische Mythen aus dem Bildungsbereich kennen, vergleichen Sie diese mit aktuellen Forschungsergebnissen und erfahren Sie, warum wissenschaftliche Befunde oft überraschender sind als Schlagzeilen dies vermuten lassen.Johannes Kepler Universität Linz17:00 - 23:00 -
 MitmachstationMehrsprachigkeit erleben. Wie vielfältig ist Sprache?Thema: GesellschaftHallo und welcome: Entdecken Sie unsere Station zur gelebten Mehrsprachigkeit! Testen Sie Ihr Wissen im Mehrsprachigkeitsquiz, hören Sie mehrsprachige Gedichte, gestalten Sie farbenfrohe Sprachenportraits und erleben Sie bei unseren „Animal Sounds“, wie vielfältig Tierlaute weltweit benannt und wahrgenommen werden. Kurzum: Freuen Sie sich auf einen spielerischen Zugang zur Sprachenvielfalt.Johannes Kepler Universität Linz17:00 - 23:00
MitmachstationMehrsprachigkeit erleben. Wie vielfältig ist Sprache?Thema: GesellschaftHallo und welcome: Entdecken Sie unsere Station zur gelebten Mehrsprachigkeit! Testen Sie Ihr Wissen im Mehrsprachigkeitsquiz, hören Sie mehrsprachige Gedichte, gestalten Sie farbenfrohe Sprachenportraits und erleben Sie bei unseren „Animal Sounds“, wie vielfältig Tierlaute weltweit benannt und wahrgenommen werden. Kurzum: Freuen Sie sich auf einen spielerischen Zugang zur Sprachenvielfalt.Johannes Kepler Universität Linz17:00 - 23:00 -
 MitmachstationAlles im Blick: Macht uns Videoüberwachung (un)sicherer?Thema: DigitalisierungVideokameras und biometrische Erkennung werden im öffentlichen Raum verwendet, um die Sicherheit zu erhöhen. Sogar im privaten Umfeld, als Türsprechanlage, als Babyphone oder als Einbruchsschutz, sind diese Technologien alltäglich geworden. Aber ist das auch sicher? Was wäre, wenn jemand Zugriff auf diese Daten bekommt? Was passiert, wenn diese Kameras gegen uns verwendet werden? Finden Sie es hier heraus!Johannes Kepler Universität Linz17:00 - 23:00
MitmachstationAlles im Blick: Macht uns Videoüberwachung (un)sicherer?Thema: DigitalisierungVideokameras und biometrische Erkennung werden im öffentlichen Raum verwendet, um die Sicherheit zu erhöhen. Sogar im privaten Umfeld, als Türsprechanlage, als Babyphone oder als Einbruchsschutz, sind diese Technologien alltäglich geworden. Aber ist das auch sicher? Was wäre, wenn jemand Zugriff auf diese Daten bekommt? Was passiert, wenn diese Kameras gegen uns verwendet werden? Finden Sie es hier heraus!Johannes Kepler Universität Linz17:00 - 23:00 -
 MitmachstationVom Angstfach zum Lernspaß: Wie spannend ist Mathematik?Thema: Digitalisierung NaturwissenschaftenDie MathCityMap ist eine Lern-App, mit der Schüler:innen mathematisches Denken praktisch erleben können. Die App verwandelt mit „Math-Trails“ Probleme der echten Welt in kleine Mathe-Aufgaben. Erleben Sie mit Smartphone und Zollstock eine Reise in die Welt der Mathematik und keine Angst: Die Aufgaben gibt’s in unterschiedlichen Schwierigkeitsgraden.Johannes Kepler Universität Linz17:00 - 23:00
MitmachstationVom Angstfach zum Lernspaß: Wie spannend ist Mathematik?Thema: Digitalisierung NaturwissenschaftenDie MathCityMap ist eine Lern-App, mit der Schüler:innen mathematisches Denken praktisch erleben können. Die App verwandelt mit „Math-Trails“ Probleme der echten Welt in kleine Mathe-Aufgaben. Erleben Sie mit Smartphone und Zollstock eine Reise in die Welt der Mathematik und keine Angst: Die Aufgaben gibt’s in unterschiedlichen Schwierigkeitsgraden.Johannes Kepler Universität Linz17:00 - 23:00 -
 MitmachstationIst die Programmierung von Robotern ein Kinderspiel?Thema: Digitalisierung GesellschaftSie blinken, fahren und sind einfach süß. Unsere Ozobots können mit bunten Linien programmiert werden und bieten Kindern den perfekten Einstieg in die Welt der Informatik und Robotik. Das Projekt Girl Bo(T)s_s möchte besonders Mädchen für die Beschäftigung mit Chancen und Gefahren digitaler Technologien begeistern. Dadurch werden Geschlechterstereotype abgebaut und vor allem: Spiel und Spaß an Programmierung erlebt.Johannes Kepler Universität Linz17:00 - 23:00
MitmachstationIst die Programmierung von Robotern ein Kinderspiel?Thema: Digitalisierung GesellschaftSie blinken, fahren und sind einfach süß. Unsere Ozobots können mit bunten Linien programmiert werden und bieten Kindern den perfekten Einstieg in die Welt der Informatik und Robotik. Das Projekt Girl Bo(T)s_s möchte besonders Mädchen für die Beschäftigung mit Chancen und Gefahren digitaler Technologien begeistern. Dadurch werden Geschlechterstereotype abgebaut und vor allem: Spiel und Spaß an Programmierung erlebt.Johannes Kepler Universität Linz17:00 - 23:00 -
 MitmachstationAlles cool? Wie beeinflussen TikTok & Co unser Selbstbild?Thema: Digitalisierung GesellschaftWährend wir stundenlang durch Instagram, TikTok und Co scrollen, nehmen wir uns kaum Zeit, über die Gefahren dieser Apps nachzudenken. Wie beeinflussen die gesehenen Inhalte unsere Ansichten und Meinungen? Im Projekt Decoded - Selbstbild reloaded schauen wir deshalb genauer hin: Wir analysieren unsere Feeds und versuchen, Social-Media-Algorithmen und unsere eigene digitale Identität besser zu verstehen.Johannes Kepler Universität Linz17:00 - 23:00
MitmachstationAlles cool? Wie beeinflussen TikTok & Co unser Selbstbild?Thema: Digitalisierung GesellschaftWährend wir stundenlang durch Instagram, TikTok und Co scrollen, nehmen wir uns kaum Zeit, über die Gefahren dieser Apps nachzudenken. Wie beeinflussen die gesehenen Inhalte unsere Ansichten und Meinungen? Im Projekt Decoded - Selbstbild reloaded schauen wir deshalb genauer hin: Wir analysieren unsere Feeds und versuchen, Social-Media-Algorithmen und unsere eigene digitale Identität besser zu verstehen.Johannes Kepler Universität Linz17:00 - 23:00 -
 MitmachstationNie zu alt: Wie können ältere Menschen fit für digitale Technik werden?Thema: Digitalisierung GesellschaftBesonders ältere Personen sind oft unsicher mit neuen digitalen Technologien. Das Projekt WISER will das ändern. Von der sicheren Smartphone-Nutzung bis zum Umgang mit Spam-Nachrichten - maßgeschneiderte Micro-Learning-Einheiten unterstützen Sie dabei, am digitalen Ball zu bleiben. Nicht nur für ältere Menschen geeignet!Johannes Kepler Universität Linz17:00 - 23:00
MitmachstationNie zu alt: Wie können ältere Menschen fit für digitale Technik werden?Thema: Digitalisierung GesellschaftBesonders ältere Personen sind oft unsicher mit neuen digitalen Technologien. Das Projekt WISER will das ändern. Von der sicheren Smartphone-Nutzung bis zum Umgang mit Spam-Nachrichten - maßgeschneiderte Micro-Learning-Einheiten unterstützen Sie dabei, am digitalen Ball zu bleiben. Nicht nur für ältere Menschen geeignet!Johannes Kepler Universität Linz17:00 - 23:00 -
 MitmachstationSo schmeckt Technik: Warum schaltet ein E-Auto schneller, als Sie Waffeln backen können?Thema: DigitalisierungZischend greifen zwei Metallplatten ineinander. Kurz warten & schon sind goldgelb gebackene Waffelherzen bereit, gegessen zu werden. In E-Autos ist es ähnlich: Dort greifen 2 rotierende Stahlplatten ineinander und koppeln Motor und Räder. Dank des an der JKU erforschten intelligenten Systems erhalten Sie maximalen Fahrkomfort. Probieren Sie beides: Backen Sie Waffeln und testen Sie die Kupplungen. Was gelingt besser?Johannes Kepler Universität Linz17:00 - 23:00
MitmachstationSo schmeckt Technik: Warum schaltet ein E-Auto schneller, als Sie Waffeln backen können?Thema: DigitalisierungZischend greifen zwei Metallplatten ineinander. Kurz warten & schon sind goldgelb gebackene Waffelherzen bereit, gegessen zu werden. In E-Autos ist es ähnlich: Dort greifen 2 rotierende Stahlplatten ineinander und koppeln Motor und Räder. Dank des an der JKU erforschten intelligenten Systems erhalten Sie maximalen Fahrkomfort. Probieren Sie beides: Backen Sie Waffeln und testen Sie die Kupplungen. Was gelingt besser?Johannes Kepler Universität Linz17:00 - 23:00
























